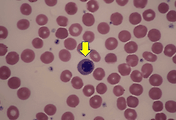

웹드라이브- 네이버 n드라이브를 보다 스마트하게 사용할수 있게 해주는 네이버 n드라이브 탐색기
지난시간 무료 웹드라이브 중에서 네이버 n드라이브와 다음클라우드에 대해 알아보았는데요.
이번시간에는 무료 웹드라이브중에서 네이버 n드라이브의 보다 확장된 기능을 살펴보도록 하겠습니다. 바로 네이버 n드라이브 탐색기가 그 주인공이군요.
참고로 네이버 n드라이브의 용량은 기본 30GB이고 부족할 경우 월 5000원으로 100GB를 추가로 할수가 있습니다.
네이버 n드라이브는 말 그대로 웹상에 c드라이브나 D 드라이브처럼 새로운 드라이브를 생성하고 활용하는 것이죠.
이러다보니 매번 접속할때마다 인터넷을 열고 로그인을 한 다음 n드라이브로 찾아들어가야지만 올려진 사진이나 문서등을 확인할수가 있습니다.
언제 어디서든 확인할수 있다는 것은 편하지만, 그래도 로그인을 해야하는 과정이 조금 귀찮게 느껴질수 있을듯 한데요.
이번시간에 알아볼 네이버 n드라이브 탐색기를 활용한다면 이런 귀찮음을 조금이나마 덜수 있습니다.
.
네이버 n드라이브 다운로드 링크: 네이버소프트웨어 바로가기
네이버 n드라이브 탐색기를 다운로드 받아서 설치한후 내컴퓨터에 네이버 n드라이브가 설치된 것을 확인할수가 있습니다.
마치 외장하드를 설치한듯한 형태로 구성되어 있죠.
이렇게 한번 설치해두면 인터넷을 열고 네이버 n드라이브를 검색한다음 로그인을 해야 하는 불편함을 해소할수 있을뿐 아니라 PC에 있는 사진이나 문서 이미지등을 공유하기에도 간편하게 사용할수가 있습니다.
또한 네이버 n드라이브는 개인당 세개의 PC에 적용이 가능하기 때문에 회사, 집, 그리고 노트북등에 설치해 두면 부족한 여유공간 때문에 생겼던 고민을 말끔히 해결할수가 있습니다.
네이버 n드라이브 탐색기는 스마트폰에서처럼 자동올리기 기능을 활용할수도 있고 공유멤버초대나 공유 URL을 이용해서 다른 사용자들과 공유하기가 가능합니다.
이런 공유기능은 회사에서 프로젝트를 진행하거나 여행일정표나 사진등을 공유하기에 적당하며, 공유 횟수에 제한을 두고 싶다면 URL만들기를 이용하면 100회에 한해서만 공유가 가능하고 그 이상이 되었을시엔 자동으로 공유가 차단되도록 할수가 있으며, 공유멤버초대와 달리 문서나 이미지등을 편집하거나 수정할수 없도록 되어 있습니다.
그리고 앞서 잠시 말씀드렸던 동기화 기능은 동기화할 PC내 폴더를 선택하고 네이버 n드라이브에 설정해둔 동기화 폴더를 선택하면 언제든지 파일을 동기화 할수가 있으며. 원하지 않을 경우 선택한 파일만 공유할수 있도록 설정할수가 있습니다.
개인적으로는 동기화보다는 파일을 선택해서 올리는 것을 추천하는데요. 아무래도 회사에서 업무중에 중요한 문서나 파일들이 공유될수도 있기 때문입니다.
직접선택해서 올리는 방법의 경우 파일을 선택해서 마우스로 드래그해서 추가하는 것만으로도 동기화가 가능하기 때문에 굳이 위험을 감수할 필요는 없을테니까요.
이번시간에 알아본 웹드라이버 서비스 네이버 n드라이브의 탐색기는 네이버 n드라이브를 보다 스마트하게 사용할수 있도록 도와줄뿐 아니라 부족한 저장공간으로 고민이었던 분들에게 더없이 좋은 해결책이 아닐까 생각이 됩니다.
'IT STORY > 소프트웨어' 카테고리의 다른 글
| nPDF- PDF파일에서 이미지추출 및 텍스트추출해주는 프로그램 (0) | 2014.11.13 |
|---|---|
| 스팀 최신버전 무료 다운로드 및 사용법-무료게임 100배 즐기기 (0) | 2014.11.12 |
| 움짤만드는법-포토스케이프의 GIF파일 만들기로 움짤만드는법(움짤 파일 첨부) (0) | 2014.11.10 |
| 인텔 칩셋 다운로드 및 사용가능한 칩셋 목록-Intel Chipset Device Software (0) | 2014.11.05 |
| avi mp4 변환프로그램[IceCream Media Converter]- avi,wmv,mkv 등 원하는 포맷으로 변환가능 (0) | 2014.10.30 |